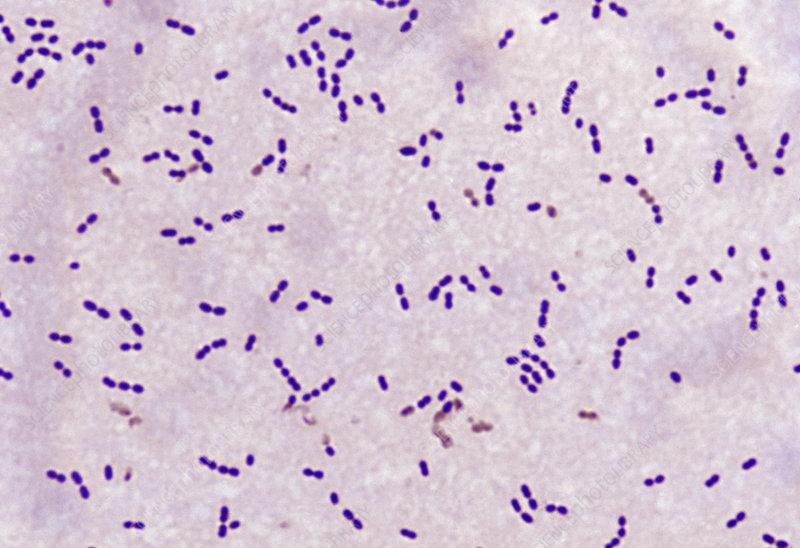

家常处理猪肉还能得脑膜炎?这种人畜共患病请小心!
2021-11-04 17:59 来源:深圳市场和质量监管


猪肉是我们日常食品
几乎每餐必备
但猪肉也会“惹祸”的哦!
如果饲养、加工、制作等环节不当
就能使人感染上猪链球菌
严重可导致脑膜炎

2005
四川发生了猪链球菌病疫情,造成了两百多人感染猪链球菌,30多人死亡。
2018
深圳一市民因处理生猪肉而感染猪链球菌。

2020
广东肇庆一名猪肉档主因为手上有伤口接触了生猪肉而感染了猪链球菌导致脑膜炎。

谈“猪”色变了吗?
大家也不用过度恐慌
近年来
深圳未出现人感染猪链球菌病的
暴发疫情或聚集性疫情
并且猪链球菌病可控可防!
具体该怎么做呢?
下面,我们对猪链球菌病一探究竟



什么是猪链球菌病?

猪链球菌病是人畜共患的、由猪链球菌感染引起的急性、热性传染病,属于国家规定的二类动物疫病。
猪链球菌属于链球菌科,链球菌属,呈圆形或卵圆形,常排列成链的革兰氏阳性球菌,共有35个血清型以及一些无法定型的菌株。其中血清2型菌株是主要的流行毒株和致病毒株,也是感染人的主要致病毒株。

猪链球菌是猪的一种常见和重要病原体,在猪群之间通过接触和呼吸传播,其主要引起猪的急性出血性败血症、化脓性淋巴结炎、脑膜炎以及关节炎等。其中,以败血症的危害最大,在某些特定诱因作用下,发病猪群的死亡率可以达到80%以上,对养猪业造成严重危害。
猪链球菌能感染人,尤其是猪链球菌2型,也是人类动物源性脑膜炎的常见病因,可引起脑膜炎、败血症、心内膜炎、关节炎和肺炎,主要表现为发热和严重的毒血症状。
猪链球菌抵抗力如何?

猪链球菌2型在环境中的抵抗力较强,可以在粪、灰尘及水中存活较长时间。100℃煮沸水可直接杀灭该菌,60℃水中该菌可存活10分钟,50℃条件下可存活2小时;但该菌对一般消毒剂敏感,常用的消毒剂和清洁剂能在1分钟内杀死细菌。

猪链球菌感染人的途径?

主要有两种形式:
(一)通过破损皮肤,创口感染。在饲养、贩运、屠宰、加工感染猪链球菌病的猪只时,通过破损皮肤接触,感染猪链球菌。
(二)通过消化道感染。食用没有煮熟的病死猪肉或者变质腐烂猪肉感染。
目前,没有发现人传人的情况出现。
人感染猪链球菌病后
临床表现有哪些?

该病潜伏期短,平均为2-3天,最短为数小时,最长13天。人感染猪链球菌后,视细菌侵入部位而有不同的临床表现,临床分为以下几种类型 。
(一)普通型:急起高热,畏寒、头痛、头昏、腹痛、腹泻,乏力不适。
(二)败血症型:除普通型症状外,还出现肢体远端皮肤瘀斑、出血,胃肠道症状,休克,后期转为多器官衰竭如心力衰竭和急性肾炎等。
(三)脑膜炎型:除普通型症状外,有恶心、剧吐,昏迷,感知性耳聋,以及运动功能失调等。


如何预防感染猪链球菌病?

(一)禁止屠宰、剖检、加工和贩卖病死猪。
(二)不要购买未经检疫或来历不明的猪肉。
(三)提倡在处理猪肉或猪肉加工过程中戴手套。皮肤如有伤口,应避免接触猪肉。
(四)不食用变质猪肉。烹饪猪肉要煮熟煮透,生熟菜板、餐具分开。
(五)如一周内有与病猪、死猪的密切接触史,并出现畏寒、高热、头痛、皮肤有出血点和呕吐等症状,应提高警惕,及时到医院就诊。
动物防疫
是人类健康的第一道防线
为了保障动物性食品的安全
防控人畜共患传染病,保障公共卫生安全
深圳市市场监管局一直在行动!
希望大家提高重视!
增强自我防护意识
若发现销售病死、未经检疫的
猪牛羊肉等相关违法行为
请迅速拨打12345向市场监管部门举报!


人畜共患病系列科普
防疫也要防炭疽!爱吃牛羊肉的请注意……
你家猫狗很可爱?咬伤你可大伤害!狂犬疫苗你打了没?
深圳为何禁售活禽?吃鸡诚可贵,防禽流感价更高……
如果你养鸟后忽然头晕想吐……“鹦鹉热”听过吗?
-END-
——————————————————
编辑:深圳市场监管
新闻来源:中国新闻周刊
如有侵权请告知删除,转载请注明以上信息

来都来了,点两个小标再走呗~






